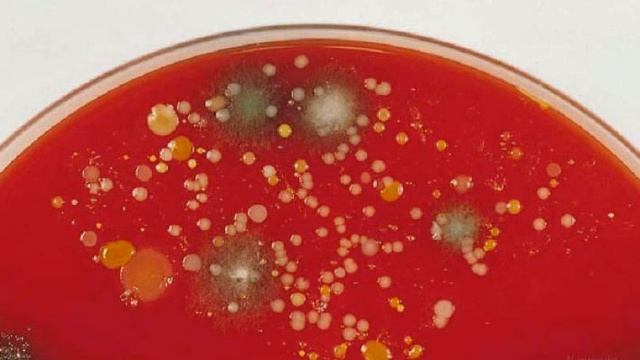
Lab 06 Bacteria in the Environment смотреть онлайн

Автор: PHP Волшебник Страница 3

Online Course Introduction: TCP/IP socket programming in C# .Net

PHP : Why is WordPress considered to be poorly programmed?

Importing Products From AliExpress To Opencart Store

Install WordPress In KSWEB Android Localhost.

Solana Up 85% In Less Than A Month!

NFS Most Wanted: Pepega Edition - V2 Update | New Cars (Pack #3)

How to install MantisBT CMS 2.15.0 on Ubuntu 18.04

Meredan v2 ElvUI Profile - Back2Game Edition for Tank & DPS

"Восточный клуб". Настольные игры Японии

Lecture53 - Intro to PHPMyAdmin - Part05

IMPRESI PERTAMA DARI NISSAN LEAF DAN IONIQ 5 | JALAN JALAN KE ACARA MOBIL LISTRIK PEVS Part 2

Final Fantasy 5 Four Job Fiesta (Part 27)

Point of Sales App using Android and Sqlite Category part 5

How to calculate the size of character integer and float data type in c language

Cryptonity ICO обзор проекта

REDIRECT HTTP TO HTTPS WITH WAMP SERVER

Fallout: New Vegas - Blind - Hardcore | Part 100, The Strip

failed to fetch http://http.kali.org/kali/dists/kali-rolling/main/contents-amd64 file has unexp....

2018 Women In Banking Forum
Lab 06 Bacteria in the Environment

Урок 7 Api – виджет
![Farming Simulator 15 #045- Süedhemmern V 8.0 - Together - [Deutsch] [4K] смотреть онлайн](https://pic.rutubelist.ru/video/3e/f7/3ef7ea5ae41f9a41ab5433d6460dbefb.jpg?size=m)
Farming Simulator 15 #045- Süedhemmern V 8.0 - Together - [Deutsch] [4K]

NBA 2k10 PC Gameplay 1991-92 Season Mod by aloncho11 (Lakers @ Bulls)

Мой пак на бравл в майнкрафт
За каждым успешным каналом стоит личность, идея и сотни часов кропотливого труда. Если вы здесь, значит, автор «PHP Волшебник» уже сумел зацепить ваше внимание своим уникальным стилем или подачей. А мы на RUVIDEO позаботились о том, чтобы вы могли изучить весь архив его работ в максимально комфортных условиях — без лишней суеты и преград.
Почему за работами канала «PHP Волшебник» так интересно наблюдать? Всё просто: это честный контент, который находит отклик в сердцах зрителей. На нашем ресурсе вы можете смотреть онлайн все видео любимого автора бесплатно и в хорошем качестве. Нам важно, чтобы вы видели каждую деталь и слышали каждый нюанс, поэтому мы используем только стабильные плееры из открытых источников Rutube.
Следите за новинками канала, пересматривайте старые шедевры и открывайте для себя новые грани творчества «PHP Волшебник». Мы постоянно обновляем ленту, чтобы у вас под рукой всегда были самые свежие выпуски. Никаких сложных регистраций — только вы и творчество, которое вдохновляет. Приятного вам путешествия по миру авторского контента на RUVIDEO!
Видео взято из открытых источников Rutube. Если вы правообладатель, обратитесь к первоисточнику.